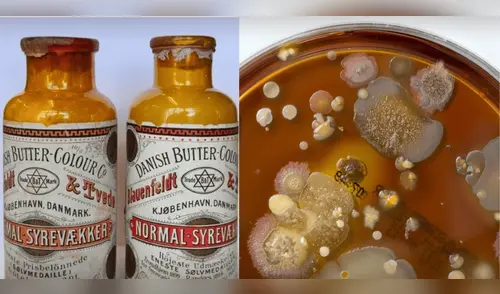
elpopular.pe

Un hallazgo impactante. Un simple frasco de mantequilla guardado hace 130 años en un sótano de la ciudad de Frederiksberg (Dinamarca) ha almacenado bacterias del siglo XIX. Un hecho que los científicos consideraban imposible, pues revela información inédita sobre la producción de lácteos durante esa época.
Según la revista International Dairy Journal, dicho recipiente fue hallado por científicos de la Universidad de Copenhague dentro de unas cajas olvidadas. Dentro del frasco se encontró un característico polvo blanquecino; el equipo no tardó en someterlo ante una secuenciación de ADN, que reveló una serie de restos de cultivos bacterianos empleados para la producción de mantequilla y otros productos lácteos durante 1890.
Científicos reviven microbios de 1890 hallados en botes de mantequilla.

PUEDES VER: Bacterias en evolución: científicos confirman la existencia de un GEN con alta resistencia a ANTIBIÓTICOS
Tras el hallazgo del frasco de mantequilla, el equipo optó por realizar nuevamente otra serie de análisis que confirmaron la existencia de Lactococcus cremoris, una bacteria empleada en la fermentación de lácteos, especialmente de la leche.
"Fue como abrir una especie de reliquia microbiológica. El hecho de que pudiéramos extraer información genética de bacterias utilizadas en la producción de mantequilla de hace 130 años fue más de lo que se esperaba", reveló Jørgen Leinser, microbiólogo y coautor del estudio.
Sin embargo, los científicos notaron que el bote era una fuente de contaminación activa, pues también se detectaron restos de Cutibacterium acnes, una bacteria común en la piel humana; asimismo, se reportó la presencia de Staphylococcus aureus y Vibrio furnissii, todas con patógenos riesgosos para el ser humano, lo que también evidenciaba los problemas de higiene durante la época.
Periodista especializada en ciencia, tecnología y salud. Bachiller en Periodismo de la Universidad Jaime Bausate y Meza. Redactora en El Popular, interesada en temas relacionados con estudios científicos, eventos astronómicos, hallazgos y más.